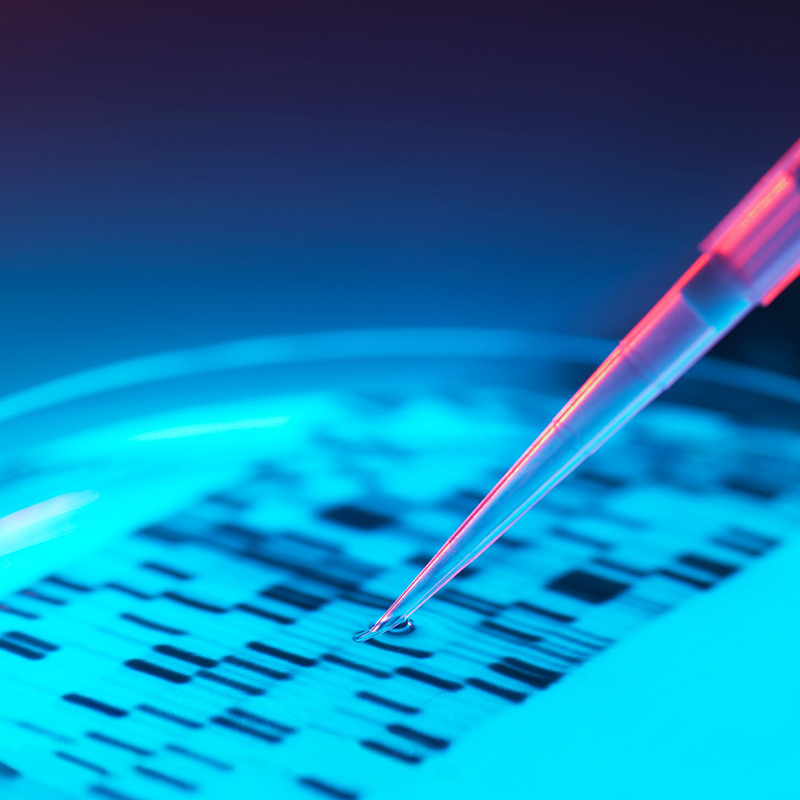

an laboratory that brings
its experience to Ukraine improving doctors and the market
its experience to Ukraine improving doctors and the market

Knowledge of DNA sequences has become indispensable for research and medical diagnosis.
The concept is based on a DNA sequence and a glass slide for analysis, which well reflect the essence of a modern laboratory.
The concept is based on a DNA sequence and a glass slide for analysis, which well reflect the essence of a modern laboratory.

blue
C90 M60 Y0 K0
R10 G97 B170
R10 G97 B170
C96 M78 Y10 K45
R26 G45 B94
R26 G45 B94
deep blue
C95 M85 Y18 K60
R28 G29 B69
R28 G29 B69
dark blue
PANTONE 300
PANTONE 662
PANTONE 101-16
— it is the process of determining the nucleic acid sequence - the order of nucleotides (adenine, guanine, cytosine and thymine) in DNA.
DNA sequencing